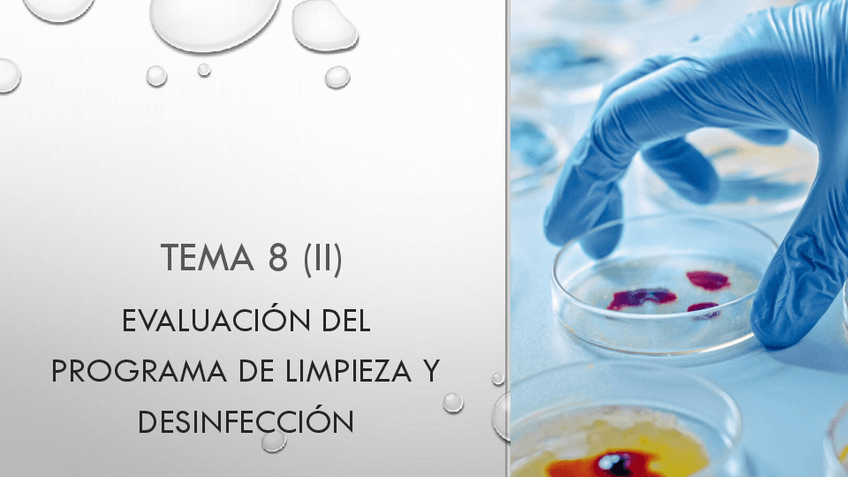

@Pescador
512 Publicaciones
3.61k Interacciones
3 Seguidores
0 Siguiendo
Lista de publicaciones de Pescador
He publicado nuevos examenes de 3º Nutrición y Dietética: Segunda-convocatoria-final.pdf
He publicado nuevos examenes de 3º Nutrición y Dietética: Preguntas-objetivos.pdf
He publicado nuevos examenes de 3º Industrias Alimentarias: PREGUNTAS-PRACTICAS-IA.pdf
examenes
-
cereales
He publicado nuevos examenes de 3º Industrias Alimentarias: cereales
apuntes
-
apuntes toxi
He publicado nuevos apuntes de 4º Higiene Alimentaria: apuntes toxi
apuntes
-
apuntes micro
He publicado nuevos apuntes de 4º Higiene Alimentaria: apuntes micro
apuntes
-
temario parasitologia
He publicado nuevos apuntes de 4º Higiene Alimentaria: temario parasitologia
apuntes
-
Tutoria_2_brote_alimentario
He publicado nuevos apuntes de 4º Higiene Alimentaria: Tutoria_2_brote_alimentario
apuntes
-
temario
He publicado nuevos apuntes de 4º Alimentación y Cultura: temario
examenes
-
EXAMEN
tutorias preguntas
apuntes
-
temario
He publicado nuevos apuntes de 4º Envases: temario